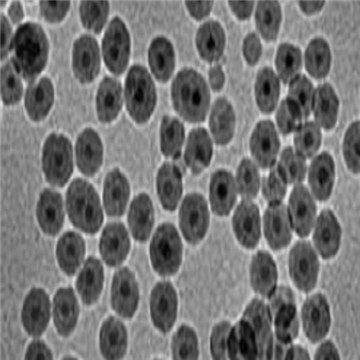
氨基磁性納米顆粒(APTES修飾)

-
- 金包磁納米顆粒(尺寸可調)
金包磁納米顆粒(尺寸可調)是一種具有核殼結構的復合納米材料,其內核為磁性納米顆粒,外層包裹著金殼層,且通過特定制備方法可實現尺寸的調節。
- 型號:
- 更新日期:2025-11-12 ¥面議
-
- PEG修飾磁性納米顆粒
PEG修飾磁性納米顆粒是一類表面經聚乙二醇(PEG)功能化的納米復合材料,核心多為 Fe?O?、γ-Fe?O?等磁性物質,兼具磁性響應與生物相容性,是生物醫學、材料科學等領域的關鍵材料。
- 型號:
- 更新日期:2025-11-10 ¥面議
-
- OA修飾Fe3O4,油酸修飾磁性納米顆粒20nm
OA修飾Fe3O4,油酸修飾磁性納米顆粒20nm是一種以四氧化三鐵(Fe?O?)為核心,表面通過油酸修飾的納米材料,粒徑約為20nm,具有優異的磁性、分散性、穩定性和生物相容性。
- 型號:
- 更新日期:2025-11-10 ¥面議